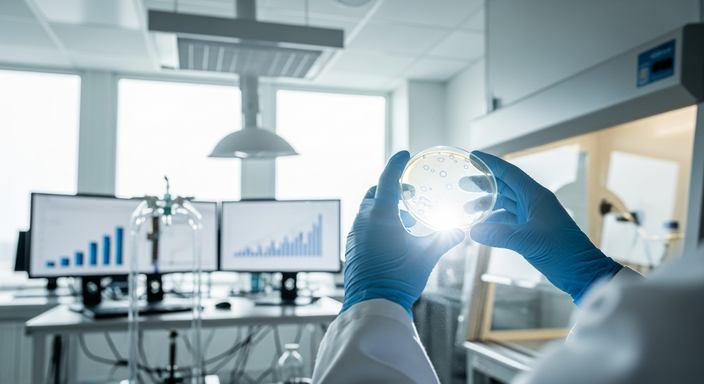
【即時新聞】處方藥銷量狂飆129％！Pelthos Therapeutics(PTHS)單季營收大增，獲利迎轉機

終端需求強勁帶動營收雙位數成長
Pelthos Therapeutics(PTHS) 執行長 Scott Plesha 表示,公司在第四季取得了重大進展。受惠於第三季推出的主力藥物 ZELSUVMI 需求強勁,實質帶動了營收的大幅成長。數據顯示,ZELSUVMI 的處方量從第三季到第四季大幅飆升 129%,總計開出 6,232 劑處方。
這項驚人的增長,直接推升淨產品營收由第三季的 710 萬美元,成長至第四季的 910 萬美元,增幅約達 28%。管理層特別強調,第四季幾乎所有的營收都來自實際提供給病患的藥物,這與第三季主要依賴上市初期鋪貨的營收結構有著顯著不同,顯示終端市場的真實需求已經開始發酵。
醫療保險覆蓋率極高推升市占率
商業總監 Sai Rangarao 指出,出貨量與處方量的表現雙雙超越內部預期,這也讓公司進一步調升了對 2026 年的內部展望。目前開立處方的獨立醫師人數已增加至 2,712 人,顯示醫師對該藥物的接受度正快速擴散。
在市場進入方面,ZELSUVMI 取得了極佳的保險給付條件,在商業醫療保險計畫中獲得了 59% 的覆蓋率,而在美國醫療補助計畫(Medicaid)的覆蓋率更是達到驚人的 99%。財務長 Francis Knuettel 補充,第四季的銷貨成本為 170 萬美元,而總額對淨額(GTN)比率為 28.7%,完全符合公司原先的預期。
擴充產品線並規劃未來上市時程
除了原有主力產品,Pelthos Therapeutics(PTHS) 也在積極擴充其產品組合。執行長強調,ZELSUVMI 擁有強大的智慧財產權保護,同時公司近期收購了 Xepi 與 Xeglyze 兩款已獲美國食品藥物管理局(FDA)批准的產品,這些被視為高度互補的生力軍。
公司預計在 2027 年 1 月正式推出 Xepi,並於 2027 年第二季末推出 Xeglyze。雖然管理層預期 ZELSUVMI 仍將是推動營收成長的主要引擎,但這兩款新產品的加入,將進一步提升未來的整體營收成長、毛利率以及獲利表現。
營運虧損大幅收斂且現金流穩健
財務數據的改善是本次財報的另一大亮點。隨著營收規模擴大,單季淨營業虧損已從第三季的 1,540 萬美元,大幅改善至第四季的 1,200 萬美元;經調整後的 EBITDA 虧損也從 1,150 萬美元收斂至 900 萬美元。
截至 12 月 31 日,公司帳上現金餘額來到 1,800 萬美元,較第三季末的 1,420 萬美元顯著增加。此外,公司在 11 月完成了 1,800 萬美元的可轉換債券融資,並於 2026 年 1 月提取了 3,000 萬美元的定期債務。管理層充滿信心地表示,目前的現金儲備足以支撐公司執行未來的商業計畫。
分析師看好營運槓桿與獲利前景
在問答環節中,分析師普遍對公司的成長性與營運槓桿抱持正面看法。針對毛利率的風險,財務長預期,隨著醫療補助計畫業務增加以及 PBM 合約的生效,未來的 GTN 比率將會朝 30% 中高段區間移動。
儘管行銷與管理費用(SG&A)會因為擴編業務團隊和準備新產品上市而暫時增加,但公司承諾將嚴格控管成本。關於市場最關心的獲利時間點,財務長透露,依據目前掌握的資訊,公司很有機會在年底前跨越損益兩平的門檻。整體而言,管理層對於 ZELSUVMI 的市場接受度感到非常滿意,並對未來的營收成長軌跡充滿信心。
公司營運簡介與近期股價表現
Pelthos Therapeutics(PTHS) 是一家處於臨床階段的生物技術公司,主要致力於開發和商業化新型、非鴉片類、無成癮性的止痛療法。其初期的臨床重點是選擇性地針對被稱為 NaV1.7 的鈉離子通道,用於治療各種類型的慢性內臟疼痛、急性和慢性眼痛,以及手術後的局部神經阻斷。
觀察個股近期交易狀況,根據 2026 年 03 月 18 日的收盤資料,Pelthos Therapeutics(PTHS) 收盤價為 24.08 美元,單日上漲 0.23 美元,漲幅達 0.96%。在交易熱度方面,當日成交量來到 4,716 股,成交量較前一個交易日暴增 435.91%,顯示市場投資人對該股的關注度正顯著升溫。
發表
我的網誌